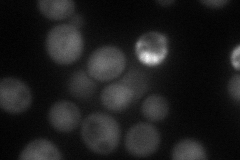
YPL149W
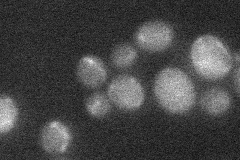
YPL149W
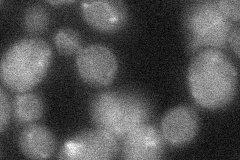
YPL149W
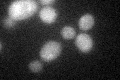
YPL149W
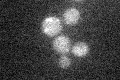
YPL149W

View description
Conserved protein involved in autophagy and the Cvt pathway; undergoes conjugation with Atg12p to form a complex involved in Atg8p lipidation; conjugated Atg12p also forms a complex with Atg16p that is essential for autophagosome formation
Localization:
Intensity:
Fold change:
Significance:
-
C’ GFP library in SD

cytosol18.68 -
N' NOP1pr-GFP in SD

cytosol,nucleus71.9283 -
N' TEF2pr-mCherry in SD
cytosol,nucleus55.3526 -
N' NATIVEpr-GFP in SD
below threshold19.3404 -
N' TEF2pr-VC and Cyto-VN in SD
below threshold26.7855 -
C’ GFP library in SD+DTT
cytosol23.731.27No -
C’ GFP library in SD+H2O2

cytosol17.230.92No -
C’ GFP library in Starvation Media
cytosol19.221.02No -
C’ GFP library on the background of Pup2-DaMP

cytosol -
C’ GFP library on the background of CCT mutant

cytosol21.94031.17416No
